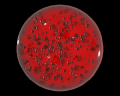
Image of Animus Orb

Transfusion Bag (1×80)
Standard (Modern)On the examination bed in the north west corner of the room.

This place is linked to the following locations:
| Location | ARK | Show on map |
|---|

There are no contents to show for this game mode. The following game modes are applicable:
